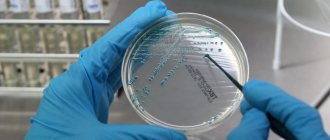

При беременности происходит полная перестройка организма, приспособление всех органов и систем к вынашиванию ребёнка. Из-за гормональных изменений, наблюдаются перепады настроения и эмоциональные расстройства.
Иммунная защита ослабевает, дают о себе знать скрытые заболевания. Частым явлением во время беременности является крапивница. Крапивница у беременных — это кожное заболевание, имеющее преимущественно аллергическую природу и проявляющееся в виде повсеместной зудящей сыпи на теле.
Симптомы крапивницы у беременных
Главным симптомом заболевания являются плоские или приподнятые волдыри, напоминающие ожог от крапивы или укус комара. Волдыри имеют неправильную округлую форму, по всему периметру окружены ярким кантом розового или красного цвета.
Количество образований постоянно растёт, они увеличиваются в размере, сливаются.
Возникают высыпания, как правило, спонтанно, на каком либо одном участке тела и постепенно распространяются повсеместно.
Изображения разнообразных проявлений крапивницы у беременных, показанные на фото, позволят быстро сравнить симптомы и начать лечение.
Большой проблемой для будущей мамы является неизменный спутник крапивных высыпаний — зуд. Проблемные места нестерпимо чешутся и днём и ночью. Женщина не может отдохнуть, полноценно выспаться, становится раздражительной.
При затяжном характере заболевания может произойти общее ухудшение состояния:
- повышается температура;
- наблюдается тошнота и рвота;
- возникают головные боли и головокружения;
- падает артериальное давление.
В целом прогноз исхода заболевания благоприятный, со временем симптомы исчезнут бесследно. Однако, случиться это может не скоро. Острая фаза длится обычно около 1 месяца, а хроническая до года.
Важно
Самым опасным последствием крапивницы является анафилактический шок и отек Квинке. Необходимо срочно вызвать скорую помощь при появлении признаков отека на лице, лающего кашля, осиплости голоса, падения давления. Любое промедление может привести к летальному исходу.
Узнать подробнее
Симптомы и признаки
Клиническая картина заболевания типичная для аллергической крапивницы и проявляется в виде:
- покраснений кожи и зуда;
- появляется сыпь и волдыри, пруритические уртикарные папулы;
- могут наблюдаться отеки лица и конечностей.
Специфично для беременных женщин, заболеванию сопутствует общее состояние нервозности, раздражительности. Нередки нарушения сна.
Локализуются внешние проявления на животе, затем перетекают на бедра и ягодицы, иногда на грудь.
На ранних сроках болезнь проявляется редко, но может быть вызвана тем, при проникновении сперматозоида в яйцеклетку, организм женщины воспринимает его как «чужого».
Фото симптомов
Как выглядит крапивница при беременности, смотрите на фото ниже:
Причины крапивницы у беременных
Причины вызывающие крапивницу у беременных можно разделить на следующие группы:
- аллергические;
- аутоиммунные;
- крапивница как симптом сопутствующего внутреннего заболевания.
Аллергические реакции
Симптомы крапивницы возникают под воздействием гистамина — активатора воспалительных процессов. Гистамин содержится в особых белых клетках крови (тучных клетках). Соединяясь с проникшим внутрь аллергеном, гистамин высвобождается из тучных клеток и вызывает воспаление и сыпь на коже.
Такой тип реакций называют немедленным, потому что первые симптомы можно заметить спустя 30 минут после контакта с аллергеном.
Виды крапивницы, протекающие по типу аллергии:
Пищевая. Аллергенами выступают продукты питания. От укусов насекомых. Веществами провокаторами являются яды. Контактная. Аллергенное вещество проникает через кожу. Например, крапивница на руках возникает при контакте с бытовой химией, на лице — с кремами и косметическими средствами. Физические: фотодерматоз (от солнца); аквагенная (от воды соприкосновения с водой); холодовая (от низких температур); механическая (от ношения тесной одежды, трения, давления).
Напрямую, аллергены в организм не попадают. Процесс выделения гистамина запускается под воздействием внешних факторов.
Аутоиммунные реакции
В этом случае крапивница возникает в результате циркуляции антител, которые иммунная система вырабатывает на свои же клетки. Подобным образом начинаются такие тяжелые заболевания как рассеянный склероз, сахарный диабет I типа, ревматоидный артрит, системная красная волчанка.
Лечение крапивницы у беременных
Лечение крапивницы при беременности должно проводиться под наблюдением врача дерматолога или аллерголога. Только доктор сможет подобрать терапию с учётом 2 важнейших принципов: облегчить состояние будущей матери и не навредить развивающемуся плоду.
Схема лечения крапивницы во время беременности заключается в решении нескольких последовательных задач:
- определение причины заболевания;
- исключение прямого контакта с факторами провокаторами болезни;
- симптоматическое лечение;
- специфическое лечение сопутствующих заболеваний и состояний.
Диагностика крапивницы у беременных
Выявление первопричины возникновения крапивницы у беременных имеет решающее значение для эффективного лечения. Специфических методов диагностики крапивницы не существует. Клинические анализы крови и мочи будут малоинформативны.
Они покажут наличие аллергической реакции в организме, но это видно и визуально. Для того чтобы отличить одну форму заболевания от другой, иногда применяют специальные диагностические тесты: аллергопробы, тест — провокация на влияние холода, солнца, физических нагрузок. Но при беременности, все они запрещены.
Поэтому, диагноз кожных высыпаний во время беременности, ставится на основании физикального осмотра и сбора анамнеза. Доктор оценивает, внешний вид и локализацию сыпи, степень тяжести состояния, давность возникновения симптомов, выявляет возможные факторы влияния.
Если причина определена правильно, лечение может не понадобиться вовсе. После устранения контакта с аллергеном, симптомы самостоятельно и бесследно исчезнут.
Основные причины проявления болезни
При возникновении аллергической реакции или любых других заболеваниях во время беременности, необходимо помнить о том, что внутренние органы поражаются из-за воздействия химических элементов. В этот период организм женщины переносит серьезные гормональные изменения. Вследствие чего развивается крапивница, которая, может привести к психологическим расстройствам. Если болезнь прогрессирует и волдыри не исчезают на протяжении нескольких дней, тогда назначается медикаментозное лечение.
Следует отметить, что иммунитет достаточно четко реагирует на каждый поступающий антиген в организм особенно в период беременности. В основном причинами возникновения крапивницы могут послужить моющие химические вещества, красители, неправильное питание. В процессе возникновения крапивницы следует исключить употребление сладкого, молочных продуктов, цитрусовых, клубники.
Медикаментозное лечение крапивницы у беременных
Недопустимо самостоятельно подбирать препараты от крапивницы при беременности, решение чем лечить принимает только доктор.
Из числа фармакологических средств для лечения крапивницы у беременных применяют:
Сорбенты. Это твёрдые вещества или жидкости, которые не перевариваются и выводятся наружу естественным путём. Проходя через пищеварительный тракт, они захватывают вредные вещества (токсины, микробы, аллергены) и очищают организм.
В целом препараты этой группы безвредны. Но во время беременности их нужно принимать только по показаниям, а не для профилактики. Ведь вместе с аллергенами, сорбенты выводят и полезные вещества, необходимые для развития плода (витамины, минералы, жидкость). Антигистаминные средства. Принцип действия этих лекарств заключается в блокировании выработки гистамина.
В результате наблюдается смягчение или исчезновение симптомов крапивницы: прекращается зуд, спадает отек и воспаление и приостанавливается образование волдырей. Правильную комбинацию препаратов этой группы подбирает доктор. Некоторые из них могут быть неэффективными, а некоторые опасными при беременности, особенно в I триместре.
Мази и кремы для местного применения. Используются для локального нанесения на отдельные участки тела, для уменьшения зуда, жжения и болевых ощущений.
Особенности протекания заболевания на разных триместрах беременности
Чаще всего крапивница в острой форме возникает на первых неделях после зачатия. Связано это с тем, что в это время иммунитет наиболее ослаблен и пытается приспособиться к пока еще чужеродному для него организму – плоду.
Усугубляется протекание аллергии и тем, что именно в первом триместре у женщин чаще всего бывает выраженный токсикоз. Лечение крапивницы на ранних сроках должно быть наиболее безопасным.
Развивающаяся на первых неделях крапивница проходит или уменьшается к началу второго триместра. Но есть опасность ее перехода в хроническую форму, обострение которой случаются при самом незначительном влиянии раздражителя.
В последние недели вынашивания крапивница может сочетаться с гестозом, поэтому ее также нельзя оставлять без внимания и лечить самостоятельно.
Средства народной медицины
Рецепты народной медицины могут быть использованы при лечении крапивницы у беременных лишь как дополнение к традиционной терапии.
Для облегчения зуда и болевых ощущений хорошо помогают отвары лекарственных трав: ромашки аптечной, календулы, череды. Смоченные в лекарственном настое ватные диски, прикладывают к местам поражения сыпью. При повсеместной локализации волдырей, можно принимать ванны с добавлением отваров трав.
Для снятия отека и воспаления можно прикладывать к больному месту ломтики огурца, сырого картофеля или листы капусты.
Для будущей матери очень важно беречься от волнений и переживаний. В качестве успокоительного средства используют листья мяты. Их добавляют в чай или делают настойку на кипятке.
Профилактика крапивницы у беременных
Во время беременности женщина несет ответственность не только за своё здоровье, но и здоровье будущего ребёнка. Приём лекарств и пребывание в стрессовом состоянии скажутся на развитии плода отрицательно. Самые элементарные меры предосторожности уберегут от такой неприятности как крапивница при беременности.
Профилактические меры:
Следить за питанием. Придерживаться специальной гипоаллергенной диеты. Отдать предпочтение блюдам домашней кухни, не пробовать незнакомые продукты. Ограничить использование косметических средств или покупать их в аптеке.
Не подвергать кожу длительному воздействию тепла или холода. Не загорать, не купаться в водоемах с холодной водой, не гулять в морозную погоду. Для открытых участков тела использовать защитные крема и мази.
Носить просторную одежду из натуральных тканей. Избегать физических нагрузок, долгих пеших прогулок, дальних поездок. Регулярно посещать участкового врача. Своевременно сдавать анализы. Не принимать лекарства без согласования с врачом.
Опасность крапивницы для организма женщины и плода
Аллергическая реакция сама по себе не оказывает практически никакого отрицательного влияния на развитие плода. Единственное, что повышается после рождения у ребенка — это склонность к аллергиям.
Но необходимо знать, что нарушить формирование органов развивающегося в утробе ребенка могут определенные медикаменты, их неправильный выбор, дозировка и продолжительность лечения. Поэтому за назначением противоаллергических и иных групп лекарств от крапивницы следует обращаться к опытному аллергологу.
Отрицательное действие аллергических реакций на организм беременной женщины объясняется и тем, что подобные заболевания из-за зуда тела и иных проявлений вызывают сильную нервозность и нарушают сон. Постоянная раздражительность, недосыпание приводят к психоэмоциональному дискомфорту, что не очень хорошо и для самой будущей мамы и для ее малыша.
Угрозу представляет и нарастающий отек Квинке. Возникающее при этом осложнении удушье без использования специальной лекарственной терапии может стать причиной летального исхода.
Нужно помнить, что у беременных все патологические процессы развиваются очень быстро, и если аллергия начала нарастать, то нужно незамедлительно вызывать скорую помощь.
Гипоаллергенная диета
Неправильное питание во время беременности — главная причина крапивницы. Соблюдение специальной гипоаллергенной диеты поможет избежать крапивницы как у будущей мамы так и у новорожденного при грудном вскармливании.
Главным принципом такой диеты является исключение из рациона продуктов, повышающих риск аллергии:
- яйца;
- мясо домашней птицы;
- рыба и морепродукты;
- цитрусовые;
- орехи;
- красные ягоды, фрукты и овощи;
- мёд;
- шоколад;
- продукты содержащие гистамин (квашеная капуста, редька, редис);
- колбасы и колбасные изделия;
- промышленные соусы (майонез, кетчуп);
- продукты с красителями и пищевыми добавками.